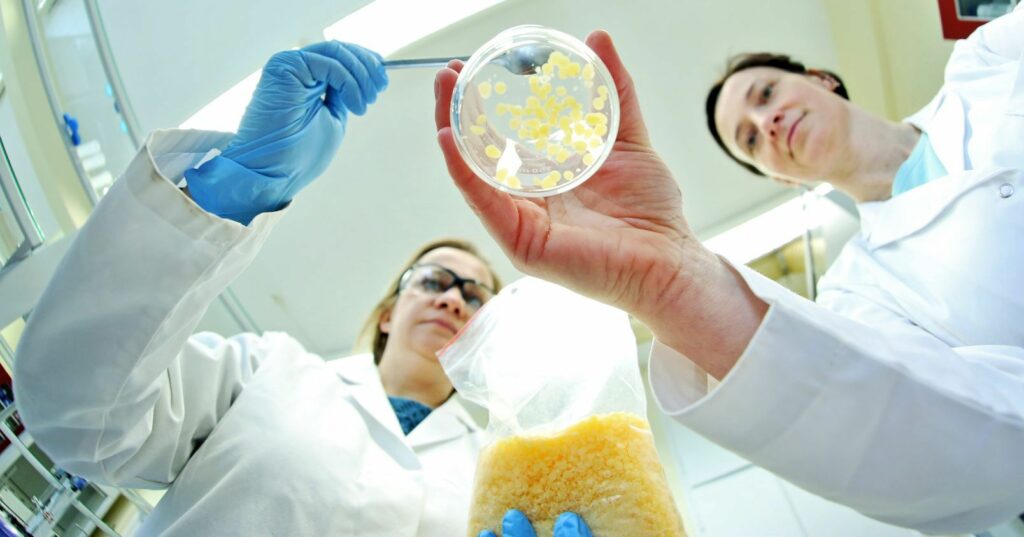

Andrzej Romański Uniwersytet Mikołąja Kopernika w Toruniu
托伦哥白尼大学的化学家开发了这种乳霜的成分,适用于黑色素瘤治疗后的皮肤需要水合作用和弹性的人。 这款化妆品将在几周内上市销售,目前已经在行业活动中获奖。
生产专用面霜的想法是偶然诞生的。 生物材料和化妆品化学系的 Beata Kaczmarek–Szczepańska 博士对具有抗癌活性的天然化合物进行了研究。 在研究过程中她发现了一种在一定浓度下可以抑制黑色素瘤发展的物质。
产品中所含的化合物已在研究中得到证实,可抑制黑色素瘤的发展。 因此该乳液可能对皮肤损伤切除的人和具有黑色素瘤遗传负担的人感兴趣。 客户中肯定也会有放疗、化疗后皮肤非常敏感、娇嫩、干燥的患者。
更多信息:
https://portal.umk.pl/pl/article/onkokosmetyki-z-naukowej-polki







